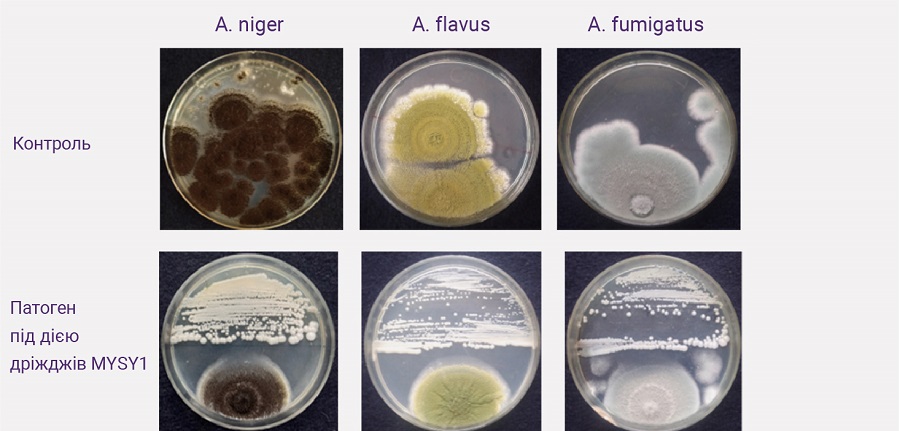
Image
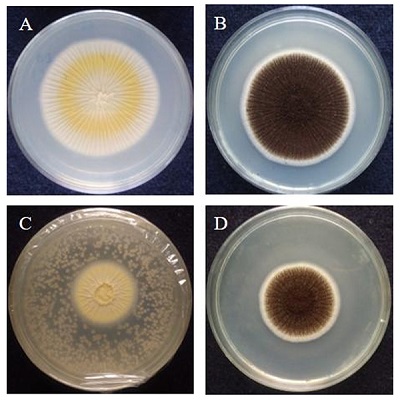
Image

Корми для птиці є ключовою статтею витрат у птахівництві, складаючи до 70% від загальної вартості. Приблизно 95% корму необхідно для задоволення потреб в енергії, силі та протеїні, близько 3-4% - для задоволення потреб у важливих поживних речовинах, мікроелементах і вітамінах, а 1-2% становлять різні кормові добавки.
За розрахунками Food and Agriculture Organization (FAO), понад 25% вироблених у світі продуктів харчування тією чи іншою мірою забруднені грибами та їхніми мікотоксинами (Sreenivasa et al., 2008; 2011 і Deepa et al., 2016). Наразі проводять дослідження з оцінки частоти забруднення мікотоксинами, і в глобальному масштабі 30% продуктів харчування та кормів для тварин є контамінованими (Magnoli et al., 2019).
Мікотоксини - це токсини, що природним чином виробляються деякими видами грибів, такими як Aspergillus, Fusarium, Penicillium, Claviceps і Alternaria. На сьогодні ідентифіковано близько 10.000 грибів, і понад 500 мікотоксинів названо потенційно небезпечними.
До найвідоміших мікотоксинів, що впливають на антропоморфи, належать афлатоксини (AF), фумонізини (FUM), охратоксини (OT), патулін (PAT), трихотецени (TCT), цитринін (CT), зеараленон (ZEN) та алкалоїди (EA) (Haque et al., 2020; Deepa et al., 2021; Adithi et al., 2022). Ці токсини привертають велику увагу через їхній потенційний згубний вплив на живі організми. Відомо, що харчові продукти, корми та зерно можуть бути забруднені безліччю різних грибів та їхніх токсинів (рис. 1) (Sreenivasa et al., 2008; Deepa and Sreenivasa, 2018; Nagaraja et al., 2016).
Рисунок 1. Різні гриби, що забруднюють корми для сільськогосподарської птиці.
A. Неконтамінований корм.
B і C. Зростання численних грибків на кормі для птиці при надходженні вологи та інкубації в темряві.
A. Неконтамінований корм.
B і C. Зростання численних грибків на кормі для птиці при надходженні вологи та інкубації в темряві.

Зростаюча увага до біобезпеки харчових продуктів призвела до застосування екологічних і біологічних підходів для знищення мікотоксинів у кормах і виробництві продуктів харчування (Luo t al., 2020).
Останнім часом біологічні підходи продемонстрували великий потенціал, забезпечуючи максимальну ефективність без будь-якого впливу на якість продукції. Численні мікроорганізми, такі як бактерії та дріжджі, довели свою користь у знезараженні кормів, забруднених мікотоксинами.
ВИКОРИСТАННЯ ДРІЖДЖІВ У ПТАХІВНИЦТВІ
Дріжджі - це одноклітинні еукаріотичні мікроорганізми діаметром 3-4 мкм (Walker et al., 2002). Серед безлічі дріжджів, штам Saccharomyces cerevisiae використовується як пробіотик або пребіотик у раціонах птиці (Hooge et al., 2004).
Численні дослідження були спрямовані на вивчення показників росту тварин і користі для здоров'я від додавання дріжджів, дріжджовмісних продуктів і компонентів на основі дріжджів у корми.
Найчастіше використовують живі сухі дріжджі, окремо або в поєднанні з корисними мікробами у вигляді пробіотичних продуктів.
Ізоляти поживних дріжджів використовуються як добавки завдяки порівняно високому вмісту білка, амінокислот, макро- і мікроелементів на відміну від звичайних кормів і олійних шротів.
Важливі продукти на основі дріжджів включають поживні сполуки, присутні в дріжджових клітинах і клітинних стінках, такі як β-глюкани, манноолігосахариди і нуклеотиди, які, як правило, сприяють зростанню і здоров'ю тварин (Shruthi et al., 2022; Shurson, 2018).

ДРІЖДЖІ ТА ЇХНІ КОМПОНЕНТИ ЯК ДОБАВКИ, ЩО ЗВ'ЯЗУЮТЬ МІКОТОКСИНИ
Токсини, що виробляються грибами, є поширеною проблемою кормовиробництва та годівлі тварин. Введення в контаміновані корми добавок, що зв'язують мікотоксини, розглядають як найефективнішу стратегію для зниження негативного впливу мікотоксинів.
Дріжджі та похідні їхньої клітинної стінки також мають певну здатність зв'язувати мікотоксини, такі як Т-2 токсин, латоксини, охратоксин А і зеараленон, пом'якшуючи їх негативний вплив на здоров'я і продуктивність тварин (Shetty and Jespersen, 2006).
Деякі дослідження показують, що пом'якшення впливу мікотоксинів за допомогою цієї стратегії досягається за рахунок адгезії мікотоксинів до компонентів клітинної стінки дріжджів (мананів і β-глюканів), а не за рахунок ковалентного зв'язування або метаболізму, оскільки інактивовані клітини не втрачають свого зв'язувального потенціалу (Baptista et al., 2004; Celyk et al., 2003).
Деякі приклади ефективності продуктів на основі дріжджів наведено нижче:
Приклад 1: Було розроблено метод оцінювання ефективності компонентів дріжджів для зниження вмісту трьох мікотоксинів: зеараленону (ZEN), охратоксину A (OTA) і афлатоксину B 1 (AFB1). Клітинна стінка пекарських дріжджів була здатна адсорбувати 68% ZEN, 62% OTA і 29% AFB1 (JoannisCassan et al., 2011).
Приклад 2: В іншому дослідженні оцінювалася здатність екстрактів стінок клітин дріжджів (ЕСКД) адсорбувати охратоксин (OTA). Птицю піддавали п'яти видам дієтичної терапії (без ОТА, з ОТА і з ОТА, доповненим ЕСКД у трьох різних дозах). Оцінювали відкладення ОТА в печінці, і отримані дані показали зниження концентрації охратоксину на 30% у печінці бройлерів, які отримували ОТА з додаванням ЕСКД (Vartiainen et al., 2020).
У дослідженні, проведеному для оцінки здатності термічно інактивованих пекарських дріжджів (ІПД), клітинної стінки (13)-b-D-глюкану пекарських дріжджів (BGBY) і клітинної стінки пекарських дріжджів (CWBY) зв'язувати AFB1 у фосфатно-буферному сольовому розчині з додаванням 0,5 мкг/мл AFB1. Зв'язування AFB1 з BGBY, CWBY і ІПД варіювалося від 6,30 до 46,34%. Максимальний потенціал зв'язування спостерігався з BGBY за часу взаємодії 24 години. CWBY мав максимальну стабільність зв'язування AFB1 після промивання буферного розчину. У результаті цього дослідження було встановлено, що BGBY є найефективнішим зв'язувачем, оскільки максимальний вплив BGBY усуває більшу кількість AFB1 (Aazami et al., 2018).
Було проведено оцінку ефективності Pichia kudriavzevii як нового дріжджового біоадсорбенту для адсорбції AFB1. Результат показал, що додавання P. kudriavzevii (0,1%) у корми для бройлерів, які забруднені AFB1, є ефективним (Magnoli et al., 2017).

Крім того, в одному з досліджень вивчалися біополімери β-D-глюкану як сполучна речовина мікотоксину для DON і FUM, а також їхній вплив на поживну цінність сої, що вважається одним з основних видів сировини для виробництва кормів. Результат показав, що ефективність біополімерів β-D-глюкану щодо поглинання FUM і DON була вищою, ніж у глини та пропіонату кальцію. Обробка насіння сої β-D-глюкановими біополімерами in vivo призвела до зниження рівня FUM і DON у насінні, штучно інокульованому F.verticillioides. Крім того, було відзначено низький вплив на поживні компоненти насіння, обробленого β-D-глюканом, порівняно з необробленим насінням (El-Naggar y Thabit, 2014).
Оцінка in vitro мікотоксинзв'язуючої здатності живих і термоінактивованих клітин Kluyveromyces marxianus QKM-4 показала зниження концентрації ОТА і ДОН (58% і 49%, відповідно) у штучно забруднених буферах.
ДРІЖДЖІ ЯК ПРОТИГРИБКОВІ АГЕНТИ
Багато штамів дріжджів, виділених із різних джерел, було досліджено для контролю росту грибків (рис. 2).
Рисунок 2. Протигрибкова активність дріжджів MYSY1 проти грибів виду Aspergillus, що продукують мікотоксини
У властивостях дріжджів задіяні різні механізми, такі як:
- секреція ферментів;
- конкуренція за поживні речовини і простір;
- виробництво токсинів;
- виділення органічних сполук;
- індукція резистентності у рослин (Delali et al., 2021).
Органічні сполуки, що виробляються дріжджами, використовувалися для боротьби з різними грибками, пов'язаними з кормами (рис. 3).
Рисунок 3. Зниження росту A. niger під дією антагоністичної активності органічних сполук, що продукуються дріжджами MYSY1.
A і B. Контрольні пластини з патогенами.
C і D. Патогенні пластини, оброблені дріжджовим ізолятом.
A і B. Контрольні пластини з патогенами.
C і D. Патогенні пластини, оброблені дріжджовим ізолятом.
Нижче наведено приклади досліджень із використанням органічних сполук:
Приклад 1: Під час дослідження оцінки продукування органічних сполук дріжджами Pichia та його впливу на Monascus purpureus використовувався метод подвійної посудної системи. Зниження росту M.purpureus становило 39,22% через 7 днів. Що стосується протигрибкових летких сполук, було встановлено, що 2-фенілетанол чинить фунгіцидну дію на M. purpureus під час контакту і без контакту (Zhang et al., 2021).
Приклад 2: В іншому дослідженні спостерігалося зниження росту M. fructicola на 76,0 і 65,8% при впливі Pichia membranaefaciens і Kluyveromyces apiculata, відповідно. Органічні сполуки, продуковані P.membranaefaciens і K.apiculata, чинили істотну репресивну дію на M. fructicola in vitro та in vivo (Zhang et al., 2017).
Приклад 3: Дріжджі Wickerhamomyces anomalus, Metschnikowia pulcherrima, Aureobasidium pullulans і Saccharomyces cerevisiae оцінили щодо їхніх антагоністичних властивостей переносити й продукувати протигрибкові органічні сполуки, як за умов in vivo, так і in vitro, під час іммобілізації на комерційних гідрогелевих сферах. Органічні сполуки з перерахованих вище дріжджових ізолятів знижували ріст Aspergillus carbonarius, Monilinia fructicola, Penicillium digitatum Alternaria alternata, Botrytis cinerea, Cladosporium spp. і Colletotrichum spp. (Oro et al., 2017).
Органічні сполуки, що продукуються досліджуваними дріжджами in vitro, пригнічували ріст міцелію Botrytis cinerea, Penicillium digitatum і P. italicum і проростання конідіїв, причому максимальна агресивна активність була виявлена для штамів W. anomalus і A. pullulans (Prafati et al., 2016).
Органічні сполуки, що продукуються досліджуваними дріжджами in vitro, пригнічували ріст міцелію Botrytis cinerea, Penicillium digitatum і P. italicum і проростання конідіїв, причому максимальна агресивна активність була виявлена для штамів W. anomalus і A. pullulans (Prafati et al., 2016).
Приклад 4: Три види дріжджів, Pichia kudriavzevii, Pichia occidentalis та Meyerozyma guilliermondii/Meyerozyma caribbica, оцінили проти поширених патогенів рослин Mucor spp., Penicillium chrysogenum, Penicillium expansum, Aspergillus flavus, Fusarium cereals, Fusarium poae, та Botrytis cinerea. Ацетатний ефір, етилові ефіри середньоланцюгових жирних кислот та фенілетиловий спирт були серед органічних сполук, що продукуються дріжджами в присутності патогенів рослин (Choinska et al., 2020).
Компанія «АгроПлюсІнвест» пропонує продукт Біолекс МВ-40, у складі якого містяться 100% клітинних стінок пивних дріжджів роду Saccharomyces cerevisiae: мананоолігосахарили та 1,3-1,6-ß-глюкан. Біолекс МВ-40 - це антибіотичний засіб, інактиватор мікотоксинів, має імуномодулюючий та пребіотичний ефекти.
- 1,3-1,6-β-глюкани - особлива фракція стінок дріжджів для активації імунної системи організму;
- Гумолони (α-кислоти), луполони (β-кислоти) і ксантогумол - важливі екстракти з хмелю, мають антибіотичну, бактерицидну дію;
- Активні мананоолігосахариди (МОС) для вибіркової адсорбції і інактивації мікотоксинів й збудників хвороб;
- Пребіотичні МОС є живильним середовищем для позитивної мікрофлори.
Продукт отриманий за спеціальною технологією компанії Leiber GmbH (Німеччина) методом екстракції з біологічно бездоганної сировини без додавання хімічних компонентів та є №1 в Європі по рівню МОС та β-глюканів.
